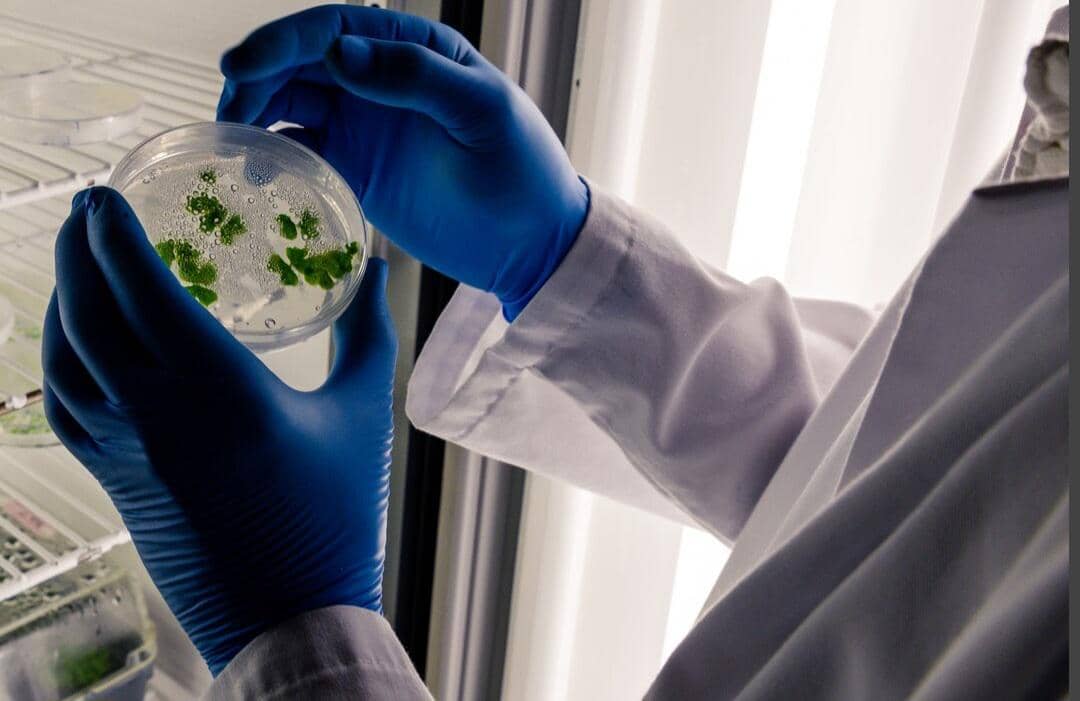
ilustrasi Bioremediasi (freepik.com/wirestock)

5 Solusi Inovatif untuk Perkebunan Kelapa Sawit Berkelanjutan

Integrasi Internet of Things (IoT) untuk presisi agrikultur
Penerapan sensor IoT memantau kondisi tanah, kelembaban, dan kesehatan tanaman secara real-time.
Data dikirim ke platform digital untuk analisis cermat dan rekomendasi spesifik.
Penggunaan air irigasi dan pupuk dapat dioptimalkan sehingga mengurangi limbah dan limpasan.
Bioremediasi menggunakan mikroorganisme lokal
Bakteri dan jamur pengurai alami menetralkan limbah pabrik kelapa sawit (POME).
Mikroba ini bekerja dengan memecah senyawa organik kompleks dan logam ber
Perkebunan kelapa sawit menghadapi dilema antara produktivitas dan keberlanjutan. Tekanan untuk berubah mendorong lahirnya berbagai inovasi kunci. Solusi teknologi dan ramah lingkungan kini menawarkan harapan baru.
Artikel ini mengulas lima solusi inovatif untuk transformasi praktik perkebunan. Tujuannya adalah menuju sistem sawit yang lebih berkelanjutan dan bertanggung jawab.
1. Integrasi Internet of Things (IoT) untuk presisi agrikultur

Melansir situs Folio3 AgTech, penerapan sensor IoT di lapangan dapat memantau kondisi tanah, kelembaban, dan kesehatan tanaman secara real-time. Data yang terkumpul dikirim ke platform digital untuk dianalisis dengan cermat. Hasil analisis ini memberikan rekomendasi yang sangat spesifik untuk setiap bagian lahan.
Dengan presisi ini, penggunaan air irigasi dan pupuk dapat dioptimalkan sehingga mengurangi limbah dan limpasan. Pemantauan dini terhadap serangan hama atau penyakit juga menjadi lebih efektif. Pada akhirnya, efisiensi sumber daya meningkat sementara dampak lingkungan menurun.
2. Bioremediasi menggunakan mikroorganisme lokalf
Mengutip Science Direct, bioremediasi memanfaatkan bakteri dan jamur pengurai alami untuk menetralkan limbah pabrik kelapa sawit (POME). Mikroba ini bekerja dengan memecah senyawa organik kompleks dan logam berat di dalam kolam limbah. Proses ini mengandalkan organisme yang sudah beradaptasi dengan lingkungan setempat.
Teknologi ini mampu mengurangi bau tidak sedap dan mempercepat proses pemurnian limbah secara signifikan. Air hasil olahan menjadi lebih aman dan berpotensi untuk digunakan kembali. Pendekatan alami ini menawarkan solusi pengolahan limbah yang lebih murah dan ramah ekosistem.
3. Sistem agroforestri integrasi sawit-sapi

Sistem integrasi ini menggabungkan perkebunan sawit dengan peternakan sapi di area yang sama. Sapi dapat memakan rumput dan tanaman penutup tanah di antara barisan kelapa sawit. Kotoran sapi kemudian diolah menjadi pupuk kompos alami untuk kebun.
Simbiosis mutualisme ini mengurangi biaya penyiangan gulma dan pemupukan kimiawi. Lahan menjadi lebih produktif dengan menghasilkan dua komoditas sekaligus, yaitu sawit dan daging. Diversifikasi ini juga meningkatkan ketahanan ekonomi petani terhadap fluktuasi harga.
4. Aplikasi drone untuk pemetaan dan pemantauan

Drone dilengkapi dengan kamera multispektral dapat memetakan luas kebun, kesehatan kanopi, dan titik panas. Data visual resolusi tinggi ini memberikan gambaran detail kondisi perkebunan dari udara. Pemetaan ini dapat dilakukan secara rutin dengan biaya operasional yang relatif terjangkau.
Informasi ini memungkinkan manajemen mendeteksi area yang stres, kekurangan nutrisi, atau terancam kebakaran dengan cepat. Tindakan penanganan dapat difokuskan hanya pada area yang bermasalah, menghemat waktu dan sumber daya. Pengawasan wilayah konservasi di dalam konsesi juga menjadi lebih efektif untuk mencegah perambahan.
5. Pengembangan pupuk hayati berbasis bakteri endofit

Bakteri endofit adalah mikroba menguntungkan yang hidup di dalam jaringan tanaman sawit. Penelitian mengembangkan formulasi pupuk hayati yang mengandung bakteri spesifik untuk sawit. Bakteri ini membantu tanaman menyerap nutrisi lebih baik dan meningkatkan ketahanan terhadap penyakit.
Penggunaan pupuk hayati dapat mengurangi ketergantungan pada pupuk kimia sintetis secara drastis. Tanah menjadi lebih sehat dan subur dalam jangka panjang karena aktivitas biologisnya meningkat. Solusi ini mendukung produktivitas sekaligus menjaga kesehatan ekosistem tanah.
Kelima solusi tersebut membuka jalan bagi praktik perkebunan yang bertanggung jawab. Integrasi teknologi hijau menjembatani kesenjangan antara profit dan pelestarian alam. Saatnya bagi seluruh pelaku industri untuk bergerak bersama mendorong perubahan ini!



















